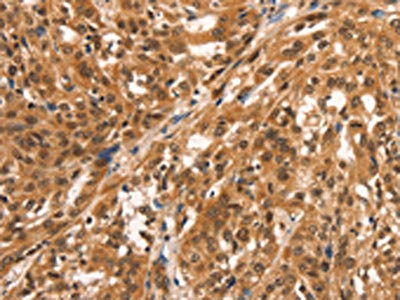

CCNE2 Antibody
-
中文名稱:CCNE2兔多克隆抗體
-
貨號(hào):CSB-PA285746
-
規(guī)格:¥1100
-
圖片:
-
The image on the left is immunohistochemistry of paraffin-embedded Human esophagus cancer tissue using CSB-PA285746(CCNE2 Antibody) at dilution 1/25, on the right is treated with synthetic peptide. (Original magnification: ×200)
-
The image on the left is immunohistochemistry of paraffin-embedded Human breast cancer tissue using CSB-PA285746(CCNE2 Antibody) at dilution 1/25, on the right is treated with synthetic peptide. (Original magnification: ×200)
-
-
其他:
產(chǎn)品詳情
-
Uniprot No.:
-
基因名:
-
別名:CCNE2 antibody; G1/S-specific cyclin-E2 antibody
-
宿主:Rabbit
-
反應(yīng)種屬:Human
-
免疫原:Synthetic peptide of Human CCNE2
-
免疫原種屬:Homo sapiens (Human)
-
標(biāo)記方式:Non-conjugated
-
抗體亞型:IgG
-
純化方式:Antigen affinity purification
-
濃度:It differs from different batches. Please contact us to confirm it.
-
保存緩沖液:-20°C, pH7.4 PBS, 0.05% NaN3, 40% Glycerol
-
產(chǎn)品提供形式:Liquid
-
應(yīng)用范圍:ELISA,IHC
-
推薦稀釋比:
Application Recommended Dilution ELISA 1:2000-1:5000 IHC 1:50-1:200 -
Protocols:
-
儲(chǔ)存條件:Upon receipt, store at -20°C or -80°C. Avoid repeated freeze.
-
貨期:Basically, we can dispatch the products out in 1-3 working days after receiving your orders. Delivery time maybe differs from different purchasing way or location, please kindly consult your local distributors for specific delivery time.
-
用途:For Research Use Only. Not for use in diagnostic or therapeutic procedures.
相關(guān)產(chǎn)品
靶點(diǎn)詳情
-
功能:Essential for the control of the cell cycle at the late G1 and early S phase.
-
基因功能參考文獻(xiàn):
- the molecular mechanism of trastuzumab action in BT474 cell line may be regulated by miR-26a and miR-30b and CCNE2 overexpression might play an important role in acquired trastuzumab resistance in HER2+ breast cancer. PMID: 28120942
- Knockdown of CCNE2 promoted MCF7 cell apoptosis and G2-stage cell cycle arrest. PMID: 30157476
- Combinatorial PX-866 and Raloxifene Decrease Rb Phosphorylation, Cyclin E2 Transcription, and Proliferation of MCF-7 Breast Cancer Cells PMID: 26660119
- The results suggest that miR30a may function as a novel tumor suppressor in CRPC. Its antioncogenic activity may occur by the reduced expression of a distinct cell cycle protein, CCNE2. PMID: 27431942
- Overexpression of cyclin E2 is an early event in gastric carcinogenesis. PMID: 27034264
- Survivin and cyclin E2 genes expression may have clinical relevance and can be considered as molecular risk factors for AL. Also they may be useful as predictive markers for treatment outcome in leukemic patients. PMID: 26600399
- miR-26a regulated mouse hepatocyte proliferation by directly targeting the 3' untranslated regions of cyclin D2/cyclin E2. PMID: 26818545
- In breast cancer patients, high levels of HMGA1 and CCNE2 expression are associated with the YAP/TAZ signature. PMID: 26265440
- data suggests the potential role of monomorphic morphology, high cyclin E2 and Ki67 expression as adverse prognostic factors for TNKLPD PMID: 25475054
- miR-144-5p functions as tumour suppressor in BC cells. CCNE1 and CCNE2 were directly regulated by miR-144-5p and might be good prognostic markers for survival of bladder cancer patients PMID: 26057453
- Our study shows miR-25 is overexpressed in small cell lung cancer and acting as oncogenic regulator by regulating cyclin E2. PMID: 25550809
- Results suggest that the miR-30d-5p/CCNE2 axis may contribute to NSCLC cell proliferation and motility. PMID: 25843294
- Data indicate that miR-26a overexpression inhibited pancreatic cancer cell growth by the downregulation of cyclin E2 expression. PMID: 24116110
- In cancer cells Fbw7, fails to effectively target cyclin E2 for proteosomal degradation. PMID: 23324394
- Cyclin E2 induction of genomic instability by a mechanism distinct from cyclin E1 indicates that these two proteins have unique functions in a cancer setting. PMID: 23324395
- protein and mRNA expressions of Cyclin E2 in nasopharyngeal carcinoma PMID: 22394640
- Tamoxifen resistant tumors displayed enriched expression of genes related to cell cycle and proliferation, as well as elevated activity of E2F transcription factors. PMID: 21789246
- expression is deregulated in primary breast tumors PMID: 12466974
- The CCNE2 qualify as independent prognostic markers for lymph node-negative breast cancer patients. PMID: 16740753
- Since SCF(Fbxw7/hCdc4) is functionally inactivated in several cancer types, alteration of this molecular pathway could contribute to the deregulation of cyclin E2 in tumorigenesis. PMID: 19084516
- A hypothetical model whereby PTEN loss upregulates cell cycle genes such as cdc6 and cyclin E2 that in turn promote metastatic colonization at distant sites. PMID: 19107233
- Data indicate that cyclin E2-Cdk2 activation by estrogen occurs via E2F- and CHD8-mediated transcription of cyclin E2 downstream of cyclin D1, and does not require c-myc. PMID: 19564413
- Investigated downregulation of coronary vascular smooth muscle cell growth by siRNA against E2F1, cyclins E1 and E2. Data shows reduction in the phosphorylation levels of the retinoblastoma protein pRB and a decrease in the amount of cyclin A2. PMID: 19603101
- Loss of cyclin D1 in ovarian cancer cells treated with SHetA2 is sufficient to induce G(1) cell cycle arrest and this strategy is not impeded by the presence of cyclin E2. PMID: 19638577
顯示更多
收起更多
-
亞細(xì)胞定位:Nucleus.
-
蛋白家族:Cyclin family, Cyclin E subfamily
-
組織特異性:According to PubMed:9858585, highest levels of expression in adult testis, thymus and brain. Lower levels in placenta, spleen and colon. Consistently elevated levels in tumor-derived cells compared to non-transformed proliferating cells. According to PubM
-
數(shù)據(jù)庫鏈接:
Most popular with customers
-
-
YWHAB Recombinant Monoclonal Antibody
Applications: ELISA, WB, IHC, IF, FC
Species Reactivity: Human, Mouse, Rat
-
Phospho-YAP1 (S127) Recombinant Monoclonal Antibody
Applications: ELISA, WB, IHC
Species Reactivity: Human
-
-
-
-
-